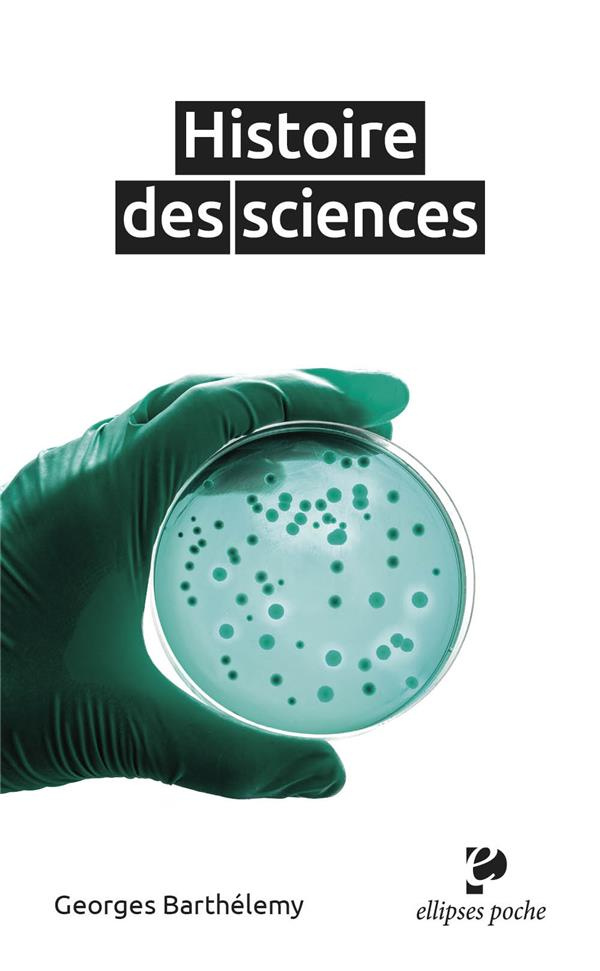
Histoire des sciences

Histoire des sciences
Barthélémy Georges
ELLIPSES
16,00 €
Sur commande
EAN :
9782340089686
On aborde généralement les sciences comme des savoirs tout faits, plus ou moins complets, plus ou moins vulgarisés. Qui a eu l'occasion de les approcher par le biais de leur histoire sait quelle satisfaction s'y peut trouver, complémentaire de celle que procure l'abord direct. L'histoire des sciences est une composante parmi d'autres de celle de l'humanité, et de celle de l'Europe tout particulièrement. En tant que branche de l'histoire des idées, et non des moindres, elle contribue à la culture scientifique, part éminente de la culture moderne. Les textes qui constituent ce livre proviennent de la collection "L'Esprit des sciences". Leur rassemblement permet de disposer d'une large vision historique.
| Nombre de pages | 745 |
|---|---|
| Date de parution | 18/06/2024 |
| Poids | 467g |
| Largeur | 110mm |
Plus d'informations
| EAN | 9782340089686 |
|---|---|
| Titre | Histoire des sciences |
| Auteur | Barthélémy Georges |
| Editeur | ELLIPSES |
| Largeur | 110 |
| Poids | 467 |
| Date de parution | 20240618 |
| Nombre de pages | 745,00 € |
Pourquoi choisir Molière ?
Efficacité et rapidité Commandé avant 16h livré demain
Économique et pratique Livraison à domicile dès 5,10 €
Facile et sans frais Retrait gratuit en magasin
Sécurité et tranquillité Paiement 100 % sécurisé
Disponibilité et écoute Contactez-nous sur WhatsApp
Du même auteur
-

Les Mathématiques, art, science et langage
Barthélémy GeorgesLa visée première de ce livre est de débrouiller ce que sont les mathématiques et de clarifier leur triple nature. Car entre l'état de simples techniques utilitaires, à l'efficacité éprouvée, et celui de pur langage formel auquel certains prétendent les réduire, elles sont aussi une science: elles ont une méthode et des objets propres.On est souvent embarrassé pour décrire l'essence de ces objets; et surtout, paradoxalement, celle des plus simples d'entre eux. L'auteur montre comment appréhender leur constitution, histoire à l'appui. Il décortique en particulier les notions de point, de ligne droite et de nombre entier.Ces analyses peuvent aider à comprendre pourquoi les mathématiques ont prise sur le réel. Elles peuvent servir également à diversifier leur enseignement. Sur la collection Collection dirigée par Georges Barthélemy.On peut souhaiter explorer les sciences autrement que par les traités ou par les cours. L'esprit des sciences permet de les aborder dans une perspective de culture scientifique: les ouvrages de cette collection sont autant d'occasions de découvrir, de comprendre et d'apprécier.Sur commandeCOMMANDER14,50 € -

Maîtriser les mathématiques
Barthélemy GeorgesRésumé : Les mathématiques du Supérieur font la part belle à la théorie, le savoir-faire en est très tributaire et l'ensemble impose une rigueur élevée. Aussi les démarches intellectuelles demandent-elles à être perfectionnées et hissées au niveau de ces exigences. L'ouvrage est avant tout destiné aux élèves des classes préparatoires et aux étudiants des premières années qui veulent gagner en efficacité ou qui souhaitent approfondir. Il expose la logique pratique des mathématiques : particularités du langage et du symbolisme, manières de penser appropriées, conceptions justes du détail et du tout, voies du bon raisonnement, approche méthodique des problèmes. On y apprend aussi à débrouiller des complications qui, dans plusieurs branches, obscurcissent les commencements. Tout bachelier désireux de prendre les devants peut s'engager dans cette étude : seules les connaissances antérieures sont indispensables. Une centaine d'exercices et leurs corrigés invitent, tout du long, à pratiquer.Sur commandeCOMMANDER16,50 € -

Histoires des sciences
Barthélémy GeorgesOn aborde généralement les sciences comme des savoirs tout faits, plus ou moins complets, plus ou moins vulgarisés. Qui a eu l'occasion de les approcher par le biais de leur histoire sait quelle satisfaction s'y peut trouver, complémentaire de celle que procure l'abord direct. L'histoire des sciences est une composante parmi d'autres de celle de l'humanité, et de celle de l'Europe tout particulièrement. En tant que branche de l'histoire des idées, et non des moindres, elle contribue à la culture scientifique, part éminente de la culture moderne. Les textes qui constituent ce livre proviennent de la collection "L'Esprit des sciences Leur rassemblement permet de disposer d'une large vision historique."Sur commandeCOMMANDER35,00 € -

2500 ANS DE MATHEMATIQUES. L'évolution des idées
Barthélémy GeorgesCollection dirigée par Georges Barthélemy.On peut souhaiter explorer les sciences autrement que par les traités ou par les cours. L'esprit des sciences permet de les aborder dans une perspective de culture scientifique: les ouvrages de cette collection sont autant d'occasions de découvrir, de comprendre et d'apprécier.Sur commandeCOMMANDER14,50 €
Du même éditeur
-

40 thèmes illustrés par le numérique pour l'agrégation interne de mathématiques. Développements, exe
Peronno SébastienCe livre présente une quarantaine de thèmes, couvrant une large partie du programme des oraux de l'agrégation interne de mathématiques. Les thèmes sont répartis en trois catégories : des illustrations pour accompagner des résultats courants ; des exercices corrigés que l'on peut adapter en exemples de cours ; des développements approfondis, présentables en deuxième partie d'entretien. Pour chacun d'entre eux, une application, au moins, est proposée avec Python, Geogebra ou LibreOffice. L'ouvrage constitue donc un point d'appui pour répondre aux attentes du jury concernant "l'usage pertinent des outils numériques". Au-delà de ce concours, il peut intéresser les candidats à l'agrégation externe ainsi que tous les enseignants et étudiants désireux d'améliorer leurs connaissances informatiques et de rendre les mathématiques avancées plus visuelles.Sur commandeCOMMANDER24,00 € -

Micro et macroéconomie. 50 fiches pour réviser et comprendre les mécanismes économiques
Denis FrançoisCet ouvrage qui couvre l'ensemble de la microéconomie et de la macroéconomie aborde chaque thème à partir d'une fiche de révision synthétique et de cas pratiques. Il s'adresse principalement aux élèves de premier cycle d'économie, de classes préparatoires, des IEP ou des écoles de commerce et des magistères. Mais il s'adresse également aux élèves de BL. Qu'apporte spécifiquement cet ouvrage ? Tout d'abord, j'ai tenu à réduire la modélisation mathématique en mettant davantage l'accent sur la compréhension des modèles comme ISLM et 060G. J'aborde aussi les bases de l'actualisation, méthode utilisée par les banques d'affaires et les fonds de gestion pour valoriser les actifs financiers. Enfin, j'aborde des cas pratiques comme la faillite du fond LTOM.Sur commandeCOMMANDER26,00 € -

Dermatologie. Entraînement
Benassaïa ErwinLa Martingale t'accompagne tout au long de tes études de médecine avec les référentiels numériques, mis à jour régulièrement !Sur commandeCOMMANDER24,00 € -

Spécialité Sciences économiques et sociales Tle
Peugnet Arnaudrie Une collection indispensable pour préparer le contrôle continu et les épreuves du Bac avec efficacité et sérénité. Vous y trouverez : Des entraînements pour le contrôle continu (CC) ; Des sujets types du Bac pour préparer les épreuves finales (EF) ; Des pistes de réflexion et des rappels ; Des corrigés rédigés pour avoir la note maximum ; Des conseils du professeur pour améliorer sa copie.Sur commandeCOMMANDER15,00 €
